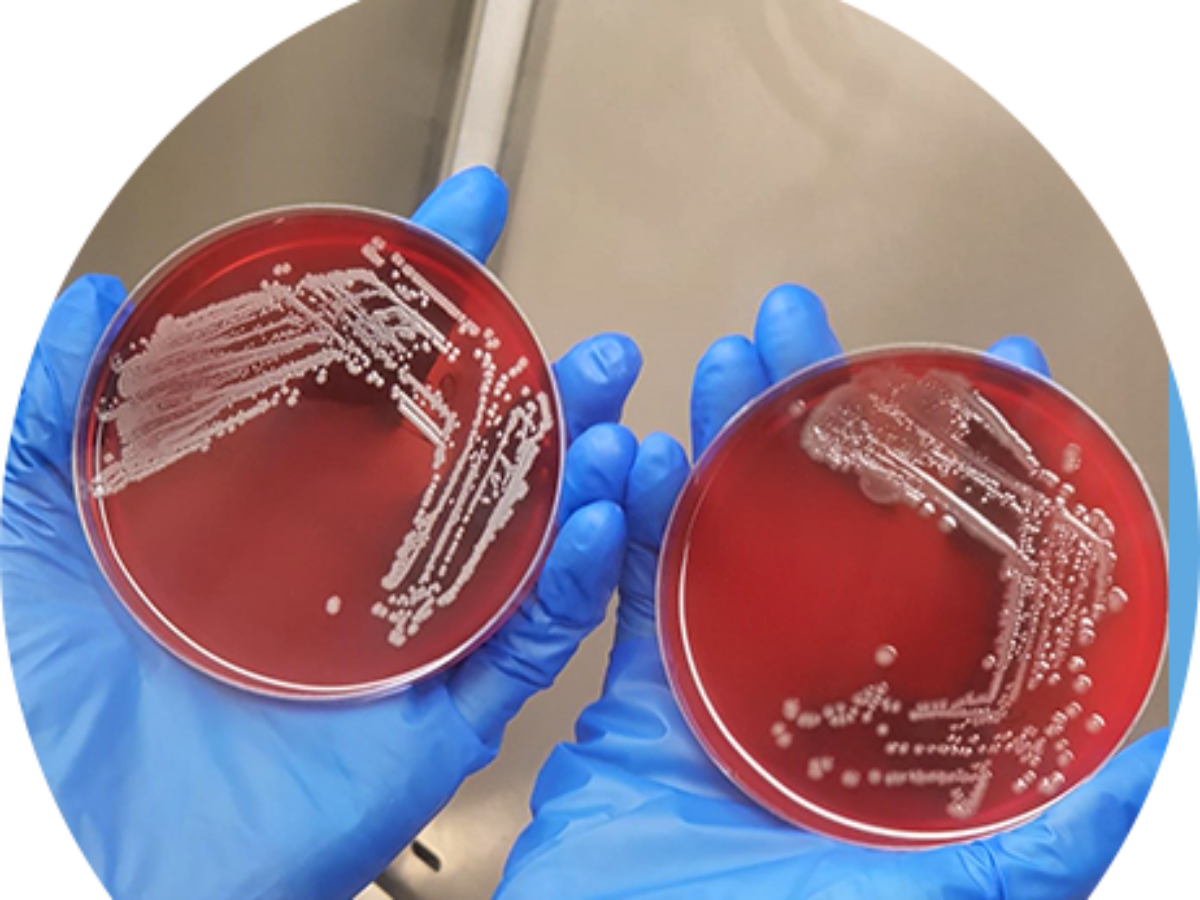

Reece Pharmaceuticals scales up manufacturing
Synthetic antibiotic developer Recce Pharmaceuticals Ltd (ASX: RCE) has scaled up its Sydney production facility to support its commercialisation activities.
The company, which has patented a new class of antibiotics to tackle resistant superbugs, has increased capacity at Macquarie Park in Sydney fivefold to cope with increasing demand.
The Company has developed an automated process to manufacture its lead compound, RECCE 327, which has undergone stage 1 and 2 clinical trials.
The scale up is needed to meet increased hospital enquiry and potential future need in stage 3, or in-human clinical trials.
Executive chairman, Graham Melrose said in a statement that data was provided to the US FDA during the first quarter of the year about its compound's chemistry, manufacturing, and controls (CMC).
RECCE 327, a treatment of blood infections and sepsis derived from E. coli and S. aureus bacteria, was further protected in the quarter with the US Patent and Trademark office granting an additional US patent.
Duiring the quarter cash outflows were $29,187 under budget.
The Company ended the quarter with cash reserves of $952,112 following a placement of $1.8 million raised from sophisticated and institutional investors in February.
Research and development focused on RECCE 327 was the largest expenditure at $560,904.
Recce has a manufacturing facility in Australia and is developing clinical research partners in the USA.
The Company expects to receive $204,408 of the research and development accrued expenditure back by way of cash advance from the federal government shortly.
Picture: Reece Pharmaceuticals
Subscribe to our free @AuManufacturing newsletter here.
Topics Manufacturing News
@aumanufacturing Sections
Analysis and Commentary Awards casino reviews Defence Gambling Manufacturing News Online Casino Podcast Technology Videos

